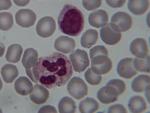
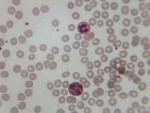
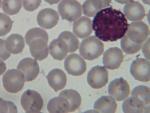

Navigazione
Esercitazione al microscopio: Gli elementi figurati del sangue
Le seguenti immagini sono state prodotte e realizzate dai ragazzi (dicembre 2006) dopo colorazione dello striscio di sangue di uno di loro (Fabio Franchi). La descrizione degli elementi raffigurati è riportata in basso (Interpretazione delle sequenze 1-48).
Si ringrazia il Dr. Michele Bisceglia (Primario Patologo dell’Ospedale Casa Sollievo della Sofferenza di S. Giovanni Rotondo – FG) per il supporto tecnico e scientifico fornito.
|
|
|
|
|
|
|
|
|
|
|
|
|
|
|
|
|
|
|
|
|
|
|
|
|
|
|
|
|
|
|
|
|
|
|
|
|
|
|
|
|
|
|
|
|
|
|
|
|
|
|
|
|
|
|
|
|
|
|
|
Interpretazione delle sequenze 1-48
1
1 2
2 3
3 4
4 5
5 6
6 7
7 8
8 9
9 10
10 11
11 12
12 13
13 14
14 15
15 16
16 17
17 18
18 19
19 20
20 21
21 22
22 23
23 24
24 25
25 26
26 27
27 28
28 29
29 30
30 31
31 32
32 33
33 34
34 35
35 36
36 37
37 38
38 39
39 40
40 41
41 42
42 43
43 44
44 45
45 46
46 47
47 48
48